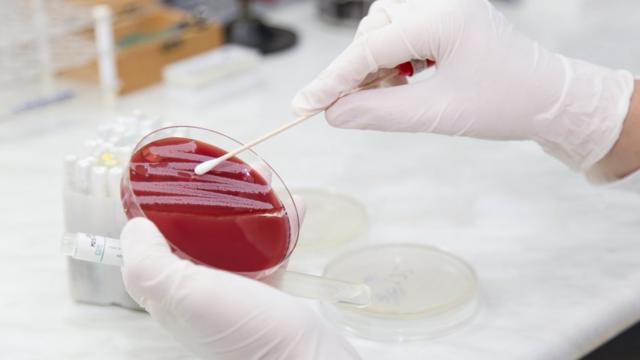
Colôniabragantino e goiás palpitesbactérias

Novo antibiótico encontrado na 'poeira' é capazbragantino e goiás palpitescombater superbactéria:bragantino e goiás palpites

Nova famíliabragantino e goiás palpitesantibióticos foi batizadabragantino e goiás palpites'maladicin' | Imagem: Science Photo Library
bragantino e goiás palpites Pesquisadores da Rockefeller University,bragantino e goiás palpitesNova York, descobrirambragantino e goiás palpitesamostras do solo recolhidasbragantino e goiás palpitesdiversos pontos dos Estados Unidos uma nova famíliabragantino e goiás palpitesantibióticos com potencial para combater infecções difíceisbragantino e goiás palpitestratar.
Testes mostraram que os compostos naturais, chamadosbragantino e goiás palpites'malacidins', foram capazesbragantino e goiás palpitesdebelar uma sériebragantino e goiás palpitesdoenças bacterianas que se tornaram resistentes à maioria dos antibióticos, entre elas a superbactéria MRSA (siglabragantino e goiás palpitesinglês que se refere à Staphylococcus aureus, que é resistente à meticilina).
Especialistas dizem que a pesquisa, divulgada na publicação científica Nature Microbiology, dá esperança na corrida para encontrar antibióticos mais efetivos.
Doenças resistentes a remédios são uma das grandes ameaças à saúde no mundo todo e matam cercabragantino e goiás palpites700 mil pessoas por ano. Por isso a pressa para encontrar novos tratamentos.
Remédio da 'poeira'
O chão está repletobragantino e goiás palpitesmicro-organismos vivos com potencial para produzir componentes terapêuticos, incluindo antibióticos.
Sean Brady, líder da equipebragantino e goiás palpitespesquisadores da Rockefeller University, é um dos cientistas dedicados a explorar o potencial medicinal da "poeira".
Seu time está usando uma técnicabragantino e goiás palpitessequenciamentobragantino e goiás palpitesgenes para analisar maisbragantino e goiás palpitesmil amostrasbragantino e goiás palpitessolo coletadasbragantino e goiás palpitestodo o território americano - e já identificou a nova famíliabragantino e goiás palpitesantibióticos, chamadabragantino e goiás palpites'malacidins',bragantino e goiás palpitesmuitas das amostras.
Eles chegaram a testar o componente naturalbragantino e goiás palpitesroedores já contaminados com bactérias resistentes, e a infecção que eles tinham na pele foi eliminada.
Agora, os cientistas estão trabalhando para melhorar o medicamento e torná-lo ainda mais eficiente, na esperançabragantino e goiás palpitesque essa nova famíliabragantino e goiás palpitesantibióticos seja usadabragantino e goiás palpitestratamentosbragantino e goiás palpiteshumanos.
Crédito, Getty Images
A pesquisa coletou mil amostrasbragantino e goiás palpitessolobragantino e goiás palpitesdiferentes lugares dos EUA
Isso, entretanto, ainda não é certo: Brady diz que a pesquisa está aindabragantino e goiás palpitesfase muito inicial e que, por isso, seria muito cedo para dizer.
"É um longo, árduo caminho entre a descoberta inicial e o uso médicobragantino e goiás palpitesum antibiótico", salienta.
O professor Colin Garner, que pesquisa antibióticos no Reino Unido, pondera que a descobertabragantino e goiás palpitesnovos antibióticos capazesbragantino e goiás palpitestratar doenças mais resistentes é uma boa noticia, mas não atende à demanda mais urgente.
"Nossa preocupação é com as bactérias chamadas gram-negativas, que são difíceisbragantino e goiás palpitestratar e cuja resistência está aumentando. Elas causam pneumonia, infeções sanguíneas e urinarias, alémbragantino e goiás palpitesinfecção na pele. Precisamosbragantino e goiás palpitesnovos antibióticos", observa Garner.




